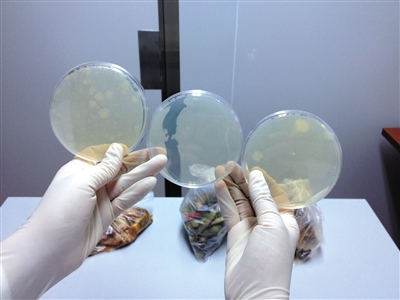
沉降采集對比 沉降采集對比

全國咨詢熱線
0532-89670500潔凈車間在日常的使用過程中,車間中的沉降離子數必須嚴格控制在相應范圍內,這樣才能對后續的凈化工作減少影響,否則可能造成整個潔凈車間運轉不正常,不能運轉等嚴重后果,那么潔凈車間沉降離子數這個參數應該如何檢測呢?接下來山東康瑞鑫凈化公司的小編就來為大家詳細講解一下潔凈車間沉降離子數的凈化檢測流程。
潔凈車間沉降離子數檢測方式一般采用沉降法,即根據沉降基本原理搜集在空氣中的微生物顆粒于培養液平皿,經一定時間采集樣本后,在適合的標準下讓其繁育到由肉眼可見的菌群后,再以平板細胞培養皿中的菌體數來判斷潔凈車間內的活微生物菌種數,并為此結果來鑒定凈化室(區)的潔凈度等級。
該沉降離子檢測法的檢測流程較為簡單易操作,一般沉降法凈化檢測分以下幾個操作步驟:
將已制取好的細胞培養皿置放在預先確定的抽樣點,開啟細胞培養皿蓋,使培養液表層曝露半個小時,再將細胞培養皿蓋緊蓋后顛倒。

▲細胞培養皿
整體時間不少于48個小時,每次培養液應該有對比實驗,查驗培養液自身是不是受環境污染,每次選中3只細胞培養皿作對比塑造。
用正常視覺計數的方式進行查數后,再用5~10倍高倍放大鏡查驗,有無忽略。若細胞培養皿上面有2個或2個之上菌體重合,可辨別時仍以2個或2個之上的菌體計數。
▲大腸桿菌48小時沉降對比
完成上述三個操作步驟后,即可完成整個潔凈車間沉降離子數的凈化檢測了。通常情況下,進行該項凈化檢測流程,還需要注意很多要求和規范。
在進行潔凈車間沉降離子數的檢測時,若使用沉降法,則需要技術人員嚴格遵循沉降法檢測技術規范進行操作,這樣才可以準確的測量潔凈車間的沉降離子數量,將檢測樣本和檢測數據做到最貼合真實情況。沉降法檢測技術規范如下:
檢測工程師務必配戴合乎該自然環境等級的工作服裝,靜態數據檢測時,房間內工作人員不可超過3人。
(1)常用的關鍵儀器設備和機器設備:髙壓滅菌鍋、恒溫培養箱、細胞培養皿(一般選用f90mm×15mm的硼酸夾層玻璃細胞培養皿)。
(2)取樣方式:將已制取好的細胞培養皿按照規定的取樣點的規定置放,開啟細胞培養皿蓋,使培養液表層曝露0.5鐘頭,再將細胞培養皿蓋上之后顛倒。
(3)菌體計數:用人眼立即計數,標識或在菌體計數器上點計,隨后用5~10高倍放大鏡查驗,是不是忽略
(4)結果測算,用計數方式得到每個細胞培養皿的菌體數。均值菌體數的測算:均值菌體數M=(M1+M2+M3+…….Mn)/n。M:均值菌體數M1:1號細胞培養皿菌體數M2:2號細胞培養皿菌體敉。Mn:n號細胞培養皿菌體數n:細胞培養皿總數。
沉降法的技術規范,比較其他方法而言,并沒有復雜,因此,只要根據技術規范進行操作,普通凈化施工人員也可進行簡單的沉降法操作。

▲潔凈車間
潔凈車間沉降法在檢測過程中,還有一些需要大家注意的地方,注意事項如下:
1、采用一切對策避免人為因素對樣版的環境污染。
2、取樣前要認真仔細每一個細胞培養皿的品質,如發覺霉變、損壞或環境污染的應去除。
3、對培養液、塑造標準以及他參數作詳盡的紀錄。
4、檢測用品要做殺菌解決,以保證檢測的穩定性、準確性。
5、因為細菌種類多種多樣,區別甚大,計數時一般用散射光于細胞培養皿反面或正臉認真觀察,不必漏計細胞培養皿邊沿生長發育的菌體,并須留意細菌菌落與培養液沉淀的差別,必需時要光學顯微鏡辨別。
好了, 本篇內容到這里就全部結束了,想必大家對潔凈車間沉降離子數的凈化檢測流程有了詳細的認知,為了能夠讓大家更好的了解潔凈車間沉降離子數的檢測方法,康瑞鑫的小編還為大家介紹了其技術標準和注意事項,讓大家可以擁有更好的參考。如果您感覺本篇文章對您有所幫助,歡迎關注我們康瑞鑫凈化公司官網中的行業快訊欄目,我們會為您持續講解各種凈化工程施工流程,介紹凈化工程各項要求,解讀各類凈化車間標準,為您提供有利參考。
聯系電話
微信掃一掃

返回頂部
Copyright 2005-2016 山東康瑞鑫凈化科技有限公司 ALL Rights Reserved